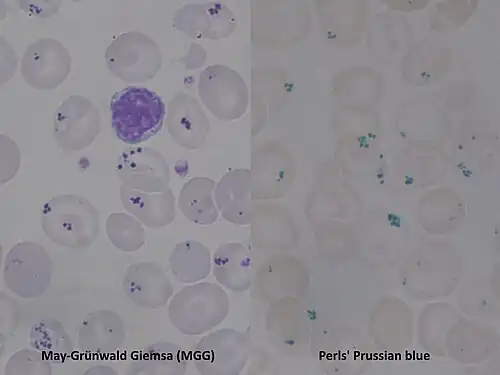

Siderocyt

Een siderocyt is een rode bloedcel met Pappenheimer-lichaampjes, die langs het celmembraan voorkomen. Het woord siderocyt is afgeleid van het Oudgriekse σίδερος (sídēros, “ijzer”). Pappenheimer lichaampjes zijn onregelmatig gevormde, korrels ferritine en komen voor bij een ineffectieve erytropoëse of ijzerhuishouding. De ferritine kleurt donkerblauw of paars bij Giemsa-kleuring.
Onvolgroeide rode bloedcellen met ferritine korrels worden sideroblasten genoemd. Deze komen voor bij sideroblastische anemie, dat ontstaat doordat het beenmerg ringvormige sideroblasten vormt in plaats van gezonde rode bloedcellen. Sideroblastische anemie kan zowel verkregen als erfelijk zijn en kan ontstaan door het gebruik van antibiotica, drugs- en alcohol en bij myelodysplasie. Erfelijke sideroblastische anemie ontstaan door een verandering in het ALAS2-gen (delta-aminolevulinate synthase 2 gen), dat op het X-chromosoom ligt.
![]() |
![]() |
Externe link
* [https://mens-en-gezondheid.infonu.nl/aandoeningen/189702-sideroblastische-anemie-bloedarmoede-met-ophoping-van-ijzer.html Mens en gezondheid. Sideroblastische anemie: bloedarmoede met ophoping van ijzer]